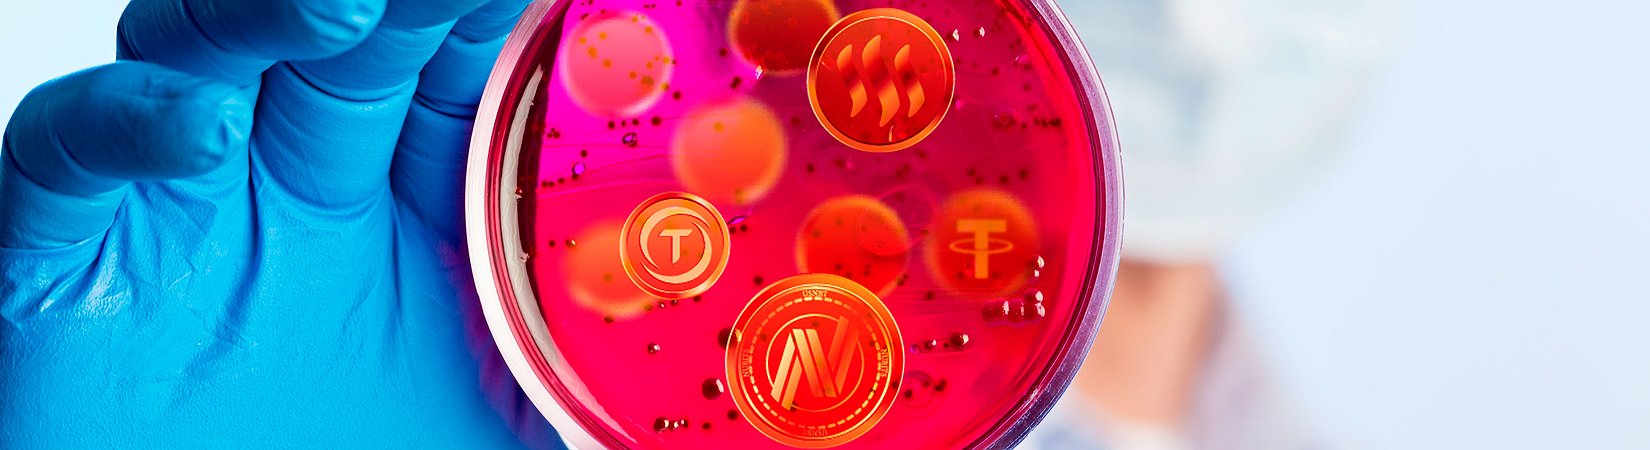
Stablecoins Under Test: All You Need to Know

Stablecoins are definitely a part of crypto narrative right now: while new coins are being introduced, the ones that are already there get listed on new crypto exchanges. CoinJar’s Asher Tan calls them “the craze” of today and Blockchain.com has devoted an almost 80-page report to this asset class. We've read it cover to cover and asked some industry experts to comment on it. Here are the key takeaways, highlighting what’s happening in the stablecoin market.
While bitcoin’s volatility is deemed to be the ‘feature’ rather than a bug, it’s still the main reason why the mass adoption of cryptocurrencies is taking longer than crypto advocates would want it to.
Designed to minimize price volatility, stablecoins are expected to become a solution to this problem. While working on this research, Blockchain.com collected over 1,600 individual data points on 57 stablecoins across 44 unique categories.
Stablecoins are usually backed by a ‘peg’, which can be fiat currencies (mostly the U.S. dollar), economic measures like indexed inflation, and commodities or other tangible assets - from gold to real estate.
Types of stablecoins
As the stablecoin market is growing, various coin designs appear. According to the report, most stablecoins can be broadly categorized as either ‘asset-backed’ or ‘algorithmic’:
“An asset-backed stablecoin design is one where some asset, most often U.S. dollars but increasingly crypto assets like ether (ETH), is held in reserve with the aim of supporting the stablecoin’s exchange rate. Tether is the most well-known live example of such a fiat-based design, and Maker Dai is the largest crypto asset-backed stablecoin.”
As the name implies, algorithmic stablecoins ‘employ a set of rules expressed in software code that attempt to match the supply of the stablecoin with demand.’
Asset-backed stablecoins represent 77% of all stablecoins, they are usually easier to market and have a somewhat simpler design, particularly those which are ‘traditional asset-backed’.
Of course, there are more complex designs like Maker’s dai stablecoin, which is backed with ether and other crypto assets. When it comes to stability benchmarks, some 66% of stablecoins use the U.S. dollar; other benchmarks comprise other fiat currencies, commodities, and inflation.
When asked why algorithmic coins are so much less popular, Matt Godshall, the editor in chief of Unhashed.com, said that when compared to the asset-backed “algorithmic stablecoins are much more abstract. Maker, for example, (which I'd consider a sort of hybrid between a crypto-backed coin and an algorithmic one) goes out of its way to tell investors that ‘Everyday users don’t need to understand the internal mechanics in order to use dai.’ The company is correct in saying this: users don't have to understand the mechanisms, though they would obviously prefer to if they could. The simplicity of asset-backed models likely makes them more appealing for a lot of investors.”
Adoption
An important part of the digital assets ecosystem, stablecoins have been in use for the past four years, reaching the total market value of $3 billion, or 1.5% of the total market value of all digital assets.
At present, stablecoins are listed on more than 50 different exchanges, with ten stablecoins (43% of live coins) being listed on one or more Tier-1 exchange.
The Blockchain.com research team stated that when talking about the use and adoption of stablecoins to date is primarily a story about Tether (USDT):
“Tether is the second most actively traded cryptocurrency, equal to approximately 60% of BTC daily trading volume. Earlier this year Tether entered the top-10 cryptoasset rankings by market value and it currently comprises 93% of the total market value of all stablecoins. Even with the success of new entrants like TrueUSD in gaining listings on major exchanges, Tether continues to dominate and commands approximately 98-99% of all stablecoin trading volume.”
When it comes to the currency trading pairs for stablecoins, Tether is also in the clear lead as at least 159 different cryptocurrencies are trading against it. The runners-up are BitUSD and dai, which have 23 and 17 crypto pairs, respectively.
In light of recent events with Tether, we asked Charlie Uchill COO of CERES Coin, whether he thinks Tether is as stable as it markets itself:
“I do not believe Tether is as stable as it markets itself...what’s scary about what happened [to Tether] on Oct 14/15 is that USDT not only traded down 15% but the number of USDT outstanding went from 2.7 Billion down to 2.2 Billion. That’s about a 22% reduction in the number of USDT out there. Tether has to maintain that market in order for people to trust what USDT is worth. And on that Sunday it didn’t happen and someone or some company profited handsomely from the failure of USDT to hold its $1 value. What protects the Tether holder? “
Other experts believe that as more major exchanges list stablecoin alternatives to Tether, its market cap will continue to shrink.
Funding
Stablecoin projects have secured $350m of funding to date, with most active investors representing two broad categories: venture capitalists including Andreessen Horowitz (investments in Basis, TrustToken, Lightspeed (SAGA), Octopus (Token) and True Ventures (Fragments) and funds solely focused on crypto assets, including Polychain Capital (Maker and Celo), Blocktower (Havven and TrueUSD), Digital Currency Group (Carbon and Token), and Pantera Capital (Fragments).
"Investors have been allocating funds across a variety of different stability mechanism designs, highlighting the diversity of views on different stablecoin designs. The off-chain asset-backed collateralized stablecoin projects TrueUSD, CENTRE (which designed USDC), SAGA, Digix, Token, and Monerium raised a combined amount of $144m, whilst non-collateralized tokens (also referred to as 'algorithmic central banks') such as Basis, Terra and Carbon have raised a combined $174m. Crypto-collateralized tokens, such as Maker Dai and Reserve, have raised the least total funds at $33m."
We asked Dean Graham, Marketing Communications Manager at STASIS, why algorithmic stablecoins raise more funds:
“Algorithmic stablecoins are Venture Capital darlings because they are something almost entirely new, and in some cases, because they are more decentralized than fiat-backed assets. They also just require more money for development upfront, because the product is so much more complicated. However, it’s worth noting that asset-backed stablecoin projects have also raised funding from VC power players such as A16z crypto.”
What’s next?
Experts believe that stablecoins will continue to evolve and contribute to a much broader adoption of digital assets, with the range of use cases for stablecoins varying from online lending and online payments to setting stable prices for in-dapp purchases.